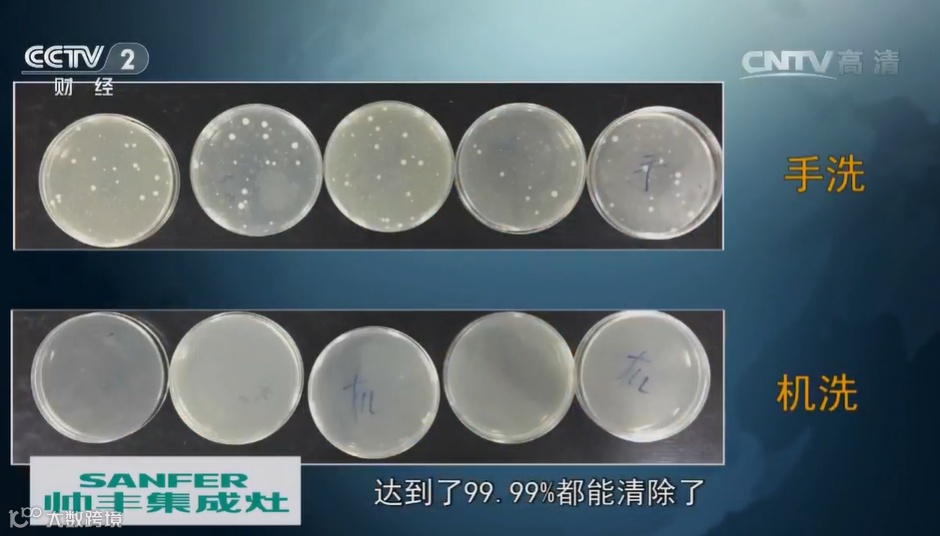

三种模式,千万别选这一种




不如说现在的喷淋式还更像“涡流”
容量大小:就高不就低



别用洗洁精!

必须有:软水盐
选其一:洗碗盐/洗碗粉/洗碗块/洗碗凝珠
最好有:亮碟剂(漂洗剂)





- ABOUT JIWUYANXUAN -
✒️
这里是「极物严选」
聚焦中国2亿中产阶级用户的精品电商
这里有10000+来自全球的尖货好物
由上百位专业买手层层把关
致力把极致好物与品质生活理念分享给你
关注极物严选,和我一起过精致而美好的生活



